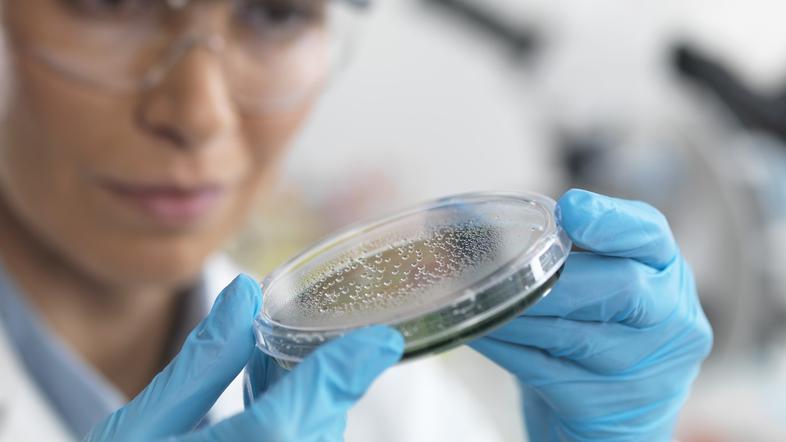
Znanstvenica v laboratoriju - raziskuje mikrodelce

V človeških tkivih, še posebej v možganih in jetrih, se je v zadnjih osmih letih bistveno povečala koncentracija mikro- in nanoplastike, kažejo izsledki študije, objavljene v reviji Nature Medicine. S pomočjo napredne infrardeče in elektronske mikroskopije so odkrili zaskrbljujoče ravni mikroplastike v možganih ljudi z demenco.
Raziskovalci so analizirali vzorce tkiv 24 oseb, umrlih leta 2024, in jih primerjali z 28 vzorci iz leta 2016, poroča nemška tiskovna agencija dpa.

Po podatkih študije je bila prisotnost plastike še posebej visoka v možganih, kjer so bile ravni do 30-krat višje kot v drugih organih, kot so jetra ali ledvice.
Čeprav so mikroplastiko že prej odkrili v organih, kot so pljuča, črevesje in celo placenta, običajna mikroskopija prepozna le delce, večje od 5 mikrometrov. To iz rezultatov izključuje manjše nanodelce, navajajo avtorji študije.
Mikrometer je tisočinka milimetra, nanometer pa milijoninka milimetra.
Campenova ekipa raziskovalcev je uporabila napredno infrardečo in elektronsko mikroskopijo, kar jim je omogočilo natančnejše zaznavanje.
Medtem ko je raven plastičnih nano- in mikrodelcev v ledvicah ostala večinoma nespremenjena, so ugotovili, da se je v jetrih in možganih povečala.
Študija je pokazala tudi zaskrbljujoče ravni mikroplastike v možganih ljudi z demenco.
Dvanajst vzorcev možganskih tkiv, zbranih med letoma 2019 in 2024, je vsebovalo od 12.000 do 48.000 mikrogramov plastike na gram tkiva.
Raziskovalci sicer opozarjajo, da je študija ugotovila korelacijo in ne neposredne vzročno-posledične povezave med prisotnostjo plastičnih delcev v možganih in demenco.

🍓 Vroča dekleta čakajo na vas na 👉 𝗦𝗲𝘅𝘁𝗼.𝗹𝗶𝗳𝗲